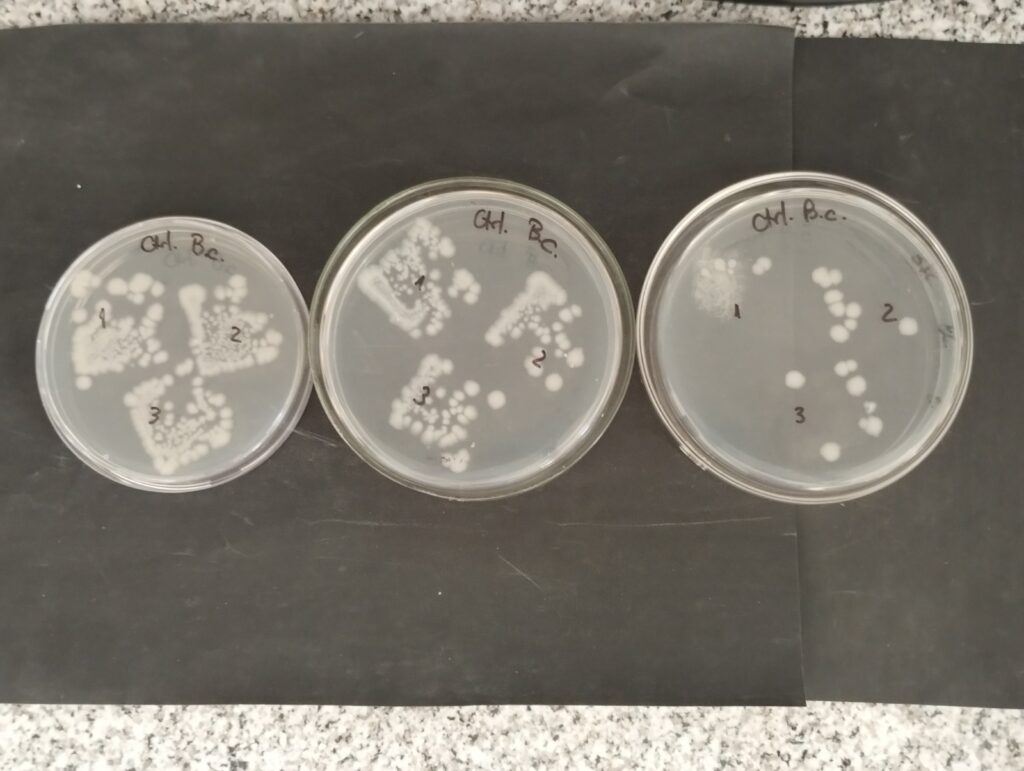

Con la preocupación de generar pinturas o recubrimientos capaces de evitar la proliferación de hongos, bacterias y algas en los ambientes, un equipo interdisciplinario del Centro de Investigación y Desarrollo en Tecnología de Pinturas (CIDEPINT), se encuentra estudiando la elaboración de recubrimientos a base de nanopartículas cargadas de productos naturales vegetales que tienen actividad antimicrobiana.
Esta investigación -financiada a través de la convocatoria Ideas Proyecto, que impulsa la Comisión de Investigaciones Científicas (CIC)- busca dar respuesta a los requerimientos de establecimientos hospitalarios, sanitarios o de la industria alimenticia, que necesitan altos estándares de seguridad higiénica.
El objetivo es que a través de los recubrimientos o pinturas pueda evitarse la formación de películas biológicas sobre distintas superficies, que no sólo pueden comprometer la durabilidad de las construcciones, si no también afectar la calidad del aire en los interiores edilicios generando la formación de bioaerosoles, que pueden tener efectos directos sobre la salud (infecciones, alergias, asma, entre otros).
Si hay agua, hay vida
“Generalmente sobre las construcciones, sean de cemento, mortero, ladrillo o madera, los microorganismos se adhieren. Allí donde exista una mínima cantidad de agua, pueden habitar la superficie y colonizarla, formando biopelículas”, explicó la doctora en Ciencias Naturales e investigadora de la CIC, Sandra Gómez de Saravia.
Este proceso es prácticamente inevitable en cualquier construcción, a menos que se utilice algún agente antimicrobiano sobre la superficie que lo bloquee. A estos agentes se los denomina biocidas y el problema es que generalmente los que se utilizan suelen ser tóxicos, por lo que pueden afectar al medio ambiente y la salud humana.
Para buscar otras variantes, se han empezado a evaluar compuestos químicos derivados o extraídos de distintos tipos de plantas, que presentan actividad antimicrobiana y además son ambientalmente sustentables. Se trata, por ejemplo, de los aceites esenciales de cannabis, romero, ajedrea, lavanda y el árbol de té; o los componentes mayoritarios presentes en éstos tales como limoneno, carvacrol, timol, pentanol o mentol.

El efecto antimicrobiano que tienen estos componentes se produce por “su capacidad de ingresar a las bacterias e interferir en su normal funcionamiento, inhibiendo la síntesis de la pared celular, la replicación de ADN, síntesis de proteínas y rutas metabólicas”, indicó la investigadora.
Si bien los resultados han sido óptimos, aparece otro problema: los biocidas de origen vegetal son volátiles, sensibles al oxígeno, luz, humedad y calor, por lo que sus propiedades pueden diluirse y su aplicabilidad no sería efectiva para este propósito.
Es ahí donde el equipo de investigación del CIDEPINT plantea una alternativa para poder emplear esas sustancias: utilizando nanotecnología. Si estos compuestos se encapsulan en nanocontenedores, pueden estar lo suficientemente protegidos para conservar la estabilidad de las sustancias bioactivas.
En ese sentido, planean utilizar dos tipos de nanopartículas: una sintética (de sílice mesoporosa) y otra de origen natural (haloisitas). Ambos sistemas presentan la capacidad de liberar las sustancias encapsuladas de manera controlada.
“Las pinturas están formadas por muchos componentes. Al incorporarles los biocidas vegetales en forma libre, interaccionan con el resto, como los pigmentos, y ocasionan la inactivación de su biopropiedad. Es por ello que incorporamos la nanotecnología en el desarrollo de nuevos recubrimientos, lo que nos permite preservar no sólo la estabilidad del biocida propia sino también de factores externos”, detalló la investigadora.

Trayectoria y experiencia
El CIDEPINT (laboratorio de triple dependencia CIC-CONICET-UNLP) cuenta con una vasta trayectoria de investigaciones orientadas al desarrollo de sistemas protectores contra la corrosión y el biodeterioro, con experiencia tanto en investigación básica como aplicada.
En este caso, el equipo de trabajo altamente especializado en la materia está conformado por profesionales de la biología, la ingeniería y la química. Además de Gómez de Saravia, lo integran la Dra. Marisa Viera (Investigadora CONICET- CIDEPINT), la Dra Elena Rastelli, (Personal de Apoyo CONICET- CIDEPINT), la Ing. Mariana Revuelta (Personal de Apoyo CIC – CIDEPINT), el Dr. Guillermo Blustein (Investigador CONICET- CIDEPINT) y el Dr. José Bengoa (Investigador CIC – CINDECA).
El propósito entonces es formular y preparar recubrimientos incorporando estas nanopartículas cargadas con productos que tienen efectos biocidas y aplicarlos en diversos materiales como placas de concreto, cemento y yeso. Luego evaluarán la capacidad protectora mediante ensayos acelerados en cámaras y bioensayos estandarizados.
La meta es generar un producto final de alto valor, funcional para estructuras constructivas que necesiten máxima seguridad higiénica, libre de aditivos tóxicos y/o contaminantes, que tenga resistencia química y además un buen y perdurable aspecto estético. La ciencia bonaerense en acción, investigando y aportando soluciones concretas de avanzada.
Por David Barresi